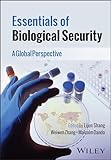
Cover image

Essentials of biological security : a global perspective / edited by Lijun Shang, Weiwen Zhang, Malcolm Dando.
Contributor(s): Shang, Lijun [editor.] | Zhang, Weiwen (Professor of microbiology and biochemical engineering) [editor.] | Dando, Malcolm [editor.]
Language: English Publisher: Hoboken, NJ : John Wiley & Sons, Inc., 2024Copyright date: ©2024Description: 1 online resource (xxxii, 288 pages) : illustrations (some color)Content type: text Media type: computer Carrier type: online resourceISBN: 9781394189014 ; 9781394189038; 1394189036; 9781394189021; 1394189028; 9781394189045; 1394189044Subject(s): BiosecurityGenre/Form: Electronic books.DDC classification: 363.325/3 LOC classification: JZ5865.B56 | E88 2024Online resources: Full text is available at Wiley Online Library Click here to view Summary: "This is a fundamental resource for life and associated scientists to raise awareness and understanding of biological security with regards to malign manipulation of scientific findings. The book is written by experts who have been engaged in biological security issues for decades, but in a systematically organized manner so that it is accessible to the wide range of different life and associated specialists who are creating the revolution in the sciences and technologies converging around the life sciences and thus radically changing our capabilities for the manipulation of living organisms for good purposes, but also opening up many more dangerous opportunities for malign manipulation ? in what has been termed dual-use applications such as novel biological and toxin weapons."-- Provided by publisher.| Item type | Current location | Home library | Call number | Status | Date due | Barcode | Item holds |
|---|---|---|---|---|---|---|---|
 EBOOK
EBOOK
|
COLLEGE LIBRARY | COLLEGE LIBRARY | 363.3253 Es745 2024 (Browse shelf) | Available |
Includes bibliographical references and index.
"This is a fundamental resource for life and associated scientists to raise awareness and understanding of biological security with regards to malign manipulation of scientific findings. The book is written by experts who have been engaged in biological security issues for decades, but in a systematically organized manner so that it is accessible to the wide range of different life and associated specialists who are creating the revolution in the sciences and technologies converging around the life sciences and thus radically changing our capabilities for the manipulation of living organisms for good purposes, but also opening up many more dangerous opportunities for malign manipulation ? in what has been termed dual-use applications such as novel biological and toxin weapons."-- Provided by publisher.
About the Author
Lijun Shang, PhD, is Professor of Biomedical Sciences in the School of Human Sciences at London Metropolitan University, UK. He is the founding Director of the Biological Security Research Centre. His research focuses primarily on ion channels in the fields of health and disease.
Weiwen Zhang, PhD, is Baiyang Chair Professor of Microbiology and Biochemical Engineering at Tianjin University of China, China. His recent research is focused on synthetic biology and governance of dual-use issues, and he currently serves as Chief Scientist of the National Key Research and Development Program of Synthetic Biology in China.
Malcolm Dando, PhD, is a Fellow of the UK Royal Society of Biology. He is Emeritus Professor at the University of Bradford, UK and is the author of Neuroscience and the Problem of Dual Use: Neuroethics in New Brain Projects.
There are no comments for this item.